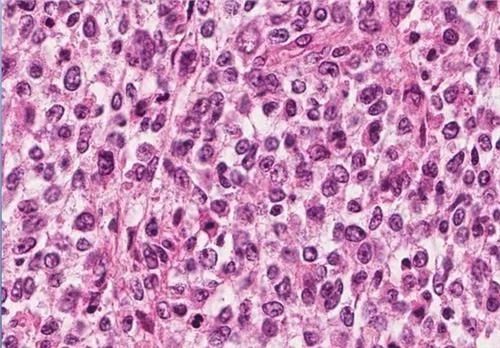
赵忠祥鳞状细胞癌长在哪,赵忠祥鳞状细胞癌什么症状

#丁香医生每日健康科普# #萌新创作者进阶计划#
1
惊闻赵忠祥的去世,我们这个年代的人从小看着他的春晚长大,印象中他一直都是那个样子,从不曾老去的模样,很感慨。很多人和场景我们觉得一直就在那里,其实我们正在经历着的人生的每个场景都非常的短暂,每一个阶段都要好好珍惜,很快就物是人非,物非人非。

2
我上网搜了一下赵老师患的什么疾病,除了写了个“鳞状细胞癌且已扩散”外没有更多的资料。可能非医学专业听起来这个名字好象陌生好象又听过,有点迷茫。首先可以肯定这个诊断是不完整的,肯定不是医院真正的诊断书看到的,估计是不懂医学的人口头传出来的。

到底什么是“鳞状细胞癌“,跟我们平时听的“肺癌”“肠癌”有什么不一样?得了这个病该怎么治疗呢?
3
我来打个比较浅显易懂的比喻,癌症的诊断就好象是某些学生考试考砸了,教育局要想知道对策和有没得治,老师们需要了解的资料是更完整和详细的。
同样的你不能走过来问我,医生,我得了癌症,该怎么治疗?医生需要的资料也是需要更完整和详细的。

比如首先我们需要知道哪个班级的,肿瘤我们需要知道哪个部位发生了问题,常听见的“肺癌”“鼻咽癌”“肠癌“就是以部位来命名的
然后我们需要知道是哪个科目的,语文?数学?英语?还是别的。
那癌症方面我们需要知道病理类型,就是病理科医生在显微镜下观察到的形态及来源,到底是这个肺这个肠哪一个组织发生的问题,是上皮?间叶?造血系统?其中来源于上皮的就分就有“鳞状细胞癌”“腺癌”等等,就是说“鳞状细胞癌”这个是一个科目的其中一个支科目。

第三我们需要知道学生考砸了砸到严重到什么程度了。1、2、3、4级砸到哪个等级了。但老师们需要找到问题解决这个考砸的问题其实只知道等级也是远远不够的,老师们还得知道你为什么把这个等级分做3级啊,到底是砸在什么地方分取得40分的分数呢。
肿瘤方面我们就需要知道分期,1、2、3、4期啊,到底到哪个期了。但是肿瘤医生单知道分期就要给出治疗方案也是不够的,我还得知道为什么分到这个等级啊,到底是什么原因分的。

4
前三条把大概的情况弄清楚了,基本诊断就可以下,比如六年级语文科目考砸了,等级为3级分数为40分。这个癌症的诊断可以下:肺鳞状细胞癌T2N1M0 III期
那接下来老师要怎么解决这个问题?那这个肺癌要怎么治呢?
作为老师其实当就这个简单的信息还是远远不够的。作为肿瘤科医生,单就这个简单的诊断还是远远不够的。
我们需要更详细的每一个细节情况。
